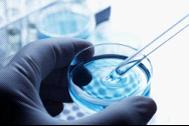
对来自炭疽菌邮件的孢子物质进行系统性微生物分析过程中,研究人员基于表型特征和形成孢子能力鉴定出多种形态变异体。

1. 伤口诱导干细胞产生癌症
研究发现潜藏在诸如毛囊之类不活跃微环境中的长寿命干细胞可能积累起导致癌症的突变,在经过诸如损伤之类引爆事件后,促进肿瘤发生。

伤口招募毛囊细胞到受伤位点,在那里下游Hh信号传导受到抑制,结果产生浅表性基底细胞癌类似的肿瘤。
根据2011年3月8日发表在PNAS期刊上一项研究,即便是一个微小肌肉伤口也能够导致之前处于潜伏状态的癌细胞发展成肿瘤。美国加州大学旧金山分校生物化学家Sunny Wong和Jeremy Reiter重点研究基底细胞癌(basal cell carcinoma)——一种与毛囊细胞相关的常见类型皮肤癌,虽然很少发生转移,也不是致命性的,但是仍然被认为是恶性的肿瘤——想知道肿瘤是如何从致癌突变发展而来的。为此,他们对小鼠进行遗传修饰以便它们的毛囊干细胞能够表达人基底细胞癌基因,然后给一些小鼠制造一个小伤口,其他的小鼠身上则没有伤口,结果他们发现只在受伤的小鼠上有肿瘤产生。
一些科学家认为这项研究是开创新的,是对抗癌症的一次激动人性的进展,认为没有什么比鉴定最为常见人类癌症起源的细胞更为重要。但是也有一些科学家对这种伤口与基底细胞瘤之间的联系存疑,因为大多数基底细胞瘤并不在损伤位点产生,因而认为这篇研究意义有限。
文献链接:Wounding mobilizes hair follicle stem cells to form tumors
2. 基因分析帮助FBI找出炭疽菌邮件攻击的来源
根据2011年3月22日发表在PNAS期刊上研究揭示通过全基因组测序鉴定出的基因标记有助于美国联邦调查局在调查炭疽菌邮件攻击时追踪细菌孢子的来源。
对来自炭疽菌邮件的孢子物质进行系统性微生物分析过程中,研究人员基于表型特征和形成孢子能力鉴定出多种形态变异体。
迪特里克港(Fort Detrick)实验室和马里兰大学医学院基因组研究所(Institute for Genomic Research)的科学家和研究人员合作研究确定2011年秋季邮件攻击中的炭疽菌来源。基于实验室样品分析,他们与美国联邦调查局(Federal Bureau of Investigation, FBI)研究人员作出结论,迪特里克港实验室研究人员Bruce E. Ivins是犯罪者。一些批评者质疑FBI的调查是否足够彻底从而排除其他可能接触到炭疽菌的实验室。
文献链接:Bacillus anthracis comparative genome analysis in support of the Amerithrax investigation
3. 大象能够在需要合作的任务中相互合作
研究揭示大象能够在需要协作行为的任务中相互合作。

这些发现表明大象在参加协作性任务时关注它们伙伴的存在和行为,揭示出存在有意合作的倾向。
2011年3月22日,发表在PNAS期刊上的一项研究,研究人员在泰国南邦市大象保护中心与12头亚洲大象呆在一起,目的是研究动物们如何相互合作以便它们每个都能有一桶玉米。当一对大象同时拉同一个绳索的两端时,携带玉米的桌子滑倒它们可触及的范围。但是,如果绳索一端在另一端之前或者另一端不拉时拉,绳索从桌子上掉下来,大象什么也得不到。
这些厚皮类动物首先学着拉桌子,然后研究人员给它们单条穿过和绕着桌子的绳索以便它们有机会与伙伴一起拉。这些大象很快就学会相互合作完成任务。研究人员还发现如果它们的伙伴不接触绳索时,它们将不会去拉绳索。相反,它们离开桌子。
文献链接:Elephants know when they need a helping trunk in a cooperative task
4. 身体疼痛和情感伤痛在我们的大脑中绑定在一起
研究表明在大脑中疼痛和排斥感可能存在着重叠的感觉机制。

根据2011年4月12日发表在PNAS期刊上的一项研究,我们的大脑很少将一个人被同事们、恋人、老板或家庭成员冷落后产生的痛苦与由于疾病或损伤引起的身体疼痛区分开来。来自美国密歇根大学、哥伦比亚大学和科罗拉多大学的研究人员让40个因为最近的关系破裂而心碎的人置于大脑扫描仪下,观察每一位被抛弃者凝视抛弃他或她的人时产生的脑电波,从而研究他或她被抛弃后产生的痛苦。在各自的扫描作业中,实验对象所产生的痛苦等同于用一根剑叶兰猛刺前臂产生的痛觉,若以10分痛觉等级来衡量的话,这种痛苦的等级为8。
研究人员用功能性磁共振成像(fMRI)扫描仪扫描实验对象,证实他们的大脑都对情感伤害和身体疼痛都对作出反应:在大脑大范围的常见区域血流增加,从而清晰地表明我们处理和经历的社会排斥感和身体疼痛存在“神经重叠”。
文献链接:Social rejection shares somatosensory representations with physical pain
5. DNA研究表明洞穴壁画很可能描述的是现实中的马
研究表明在旧石器时代壁画(Paleolithic cave)中一些斑点马可能是基于当时这种动物的现实生活存在而描绘的。

法国Pech-Merle山洞古老壁画中存在栩栩如生的“斑点马”图案,此前研究人员曾认为这可能是只是人类早期艺术绘画,实际上并不存在。但是2011年11月15发表在PNAS期刊上一项研究,科学家采用非常现代的DNA技术分析后表明壁画中的斑点马不是虚构的东西,这种斑点马生活在25000年前欧洲西部。
最新DNA证据表明一种基因突变导致马皮肤上出现黑白相间斑点的独特图案。英国约克大学研究人员和国际研究同事对跨越法国至西伯利亚地区的欧洲15个考古遗址的31个野生马化石进行了DNA分析,结果显示其中6个野生马化石共同拥有“斑点皮肤”基因。在来自欧洲西部的10个野生马化石,有4个野生马化石拥有“斑点”基因,这表明这些远古野生马在当时拥有共同的祖先。其他两个匹配野生马化石发现于现代乌克兰,很可能是由贸易行为运送到该地区。
文献链接:Genotypes of predomestic horses match phenotypes painted in Paleolithic works of cave art
6. 当父亲可能降低男人的睾丸激素水平
研究人员发现,在那些需要雄性照顾年轻后代的物种中,雄性在交配期间睾丸激素经常处于高水平,但是随后下降以便照顾后代。

根据2011年9月27日发表在PNAS期刊上的一项研究发现:当男人变成父亲之后,睾丸激素水平下降,而且花费最多时间照顾孩子的男人睾丸激素水平最低,因而从激素上讲,变成父亲可能让男人丧失一些男人的特征。但是也不用为人类担心,因为这些结果表明男人是进化上准备帮助照顾小孩,而睾丸激素可能以这种方式发挥作用。该研究也是第一次表明父亲在照顾孩子上角色直接与睾丸激素产生相关联。
文献链接:Longitudinal evidence that fatherhood decreases testosterone in human males
7. 研究人员创建大肠杆菌微生物印刷阵列密写信息
根据一项研究报道,就像活生生消失的墨水一样,研究人员设计出编码信息的细菌。

当暴露在特定波长光照射下,荧光蛋白发光,这样成组表达这些蛋白的细菌就以可见的颜色点方式发光
根据2011年10月4日发表在PNAS杂志上的一项研究,研究人员为生物技术时代开发出一种隐性墨水,该技术是通过接种加密图案的细菌在成片看似纸张那样的纤维素薄片上来实现的,其中细菌是经过基因工程改造的,能在一定条件下发光。美国塔夫茨大学化学家 David Walt和Manuel Palacios一起开发了这种加密系统,他们把这种系统称为信息生物学(InfoBiology)。
在紫外线照射能发光的荧光蛋白是一些选定的基因表达的,广泛用于基因研究中以便监视基因活性。Walt研究小组设计了七种大肠杆菌菌株,每种发出不同颜色的光。就七种不同颜色光组合的细菌文库而言,一个简单的密码检索本就产生了,比如一个绿色光细菌单元和一个橙色光细菌单元组合在一起就是代表字母“I”,而红光和绿光组合在一起就意味着字母“S”。
研究人员然后将他们的细菌接种在琼脂糖板上加密的点图案上。一旦细菌生长,他们就把一张富含营养物的纤维素薄片压在板子上面,因而也在薄片上接种同样图案的细菌。
当把这种薄片按压在一块新鲜的琼脂糖板上,细菌又再次发生转移。在荧光灯上观察,任何人都可以根据密码检索本对板上加密的信息解码。如果将荧光启动子靶向特定的目的基因,这又可以再提高信息安全水平。
Walt研究小组把荧光加入抗生素抗性基因,这样信息只在含有氨苄西林(ampicillin)的琼脂糖板子上才能观察到。Walt说,大多数对一种刺激——比如极端冷或热,或者其他营养成分或化学物——作出反应的任何基因也能够以同样方式使用。另外,也可能让利用基因改造过的大肠杆菌随着时间的流逝丢失它们的荧光性质。
文献链接:InfoBiology by printed arrays of microorganism colonies for timed and on-demand release of messages
